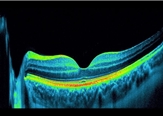

Poliklinika i optika Fokus
Vinka Međerala 9, 42 000 Varaždin
Učinite svoj vid kristalno bistrim
Učinite svoj vid kristalno bistrim
Objavljeno: 28.3.2023. 13:47




Za više informacija posjetite našu web stranicu.